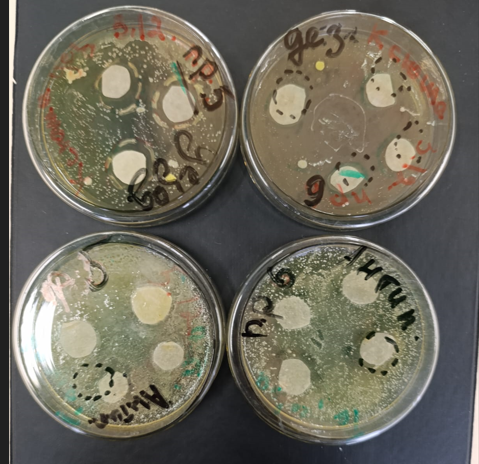
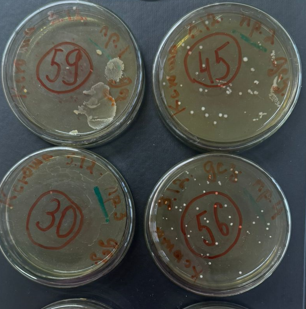

Природа или химия

Проект сравнительного анализа качества натуральных и ненатуральных дезодорантов и антиперспирантов.
_________________________
Команда
- Тедеева Арина
- Гариева Ксения
Проблема
Проблема запаха пота и повышенного потоотделения (гипергидроз) довольно распространена и может вызывать значительные неудобства как в физическом, так и в эмоциональном плане. Давайте разберемся с корнями этих проблем. Запах пота обусловлен взаимодействием пота с бактериями, которые живут на коже. Пот сам по себе не имеет запаха, но когда он начинает разлагаться под воздействием бактерий, возникают неприятные запахи.
Хотя потоотделение и запах пота — это нормальный физиологический процесс, его чрезмерное количество может вызывать дискомфорт. Поэтому люди придумали дезодоранты и антиперспиранты с натуральными и ненатуральными составами.
Проблема выбора между натуральным и ненатуральным дезодорантом стала особенно актуальной в последнее время. в частности среди потребителей, стремящихся следить за своим здоровьем и окружающей средой.
Хотя потоотделение и запах пота — это нормальный физиологический процесс, его чрезмерное количество может вызывать дискомфорт. Поэтому люди придумали дезодоранты и антиперспиранты с натуральными и ненатуральными составами.
Проблема выбора между натуральным и ненатуральным дезодорантом стала особенно актуальной в последнее время. в частности среди потребителей, стремящихся следить за своим здоровьем и окружающей средой.
Плюсы
Плюсы
- Маскирует запах пота
- Не блокирует потовые железы,позволяя телу естественно отводить тепло
- Отсутствие химических веществ
- Эффективность в борьбе с излишней потливостью
- Обеспечивает длительный эффект
Минусы
- Химический состав может вызывать раздражение кожи и аллергические реакции
- Вызывают появление пятен на одежде
- Может уменьшить количество бактерий в подмышечных впадинах, которые защищают нас от патогенов
- Не предотвращают потоотделение
- Не очень длительный эффект
- Не все дезодоранты эффективно справляются с сильным запахом пота
VS
Минусы
Актуальность
Информация о дезодорантах и антиперспирантах остается важной для покупателей, которые хотят быть в курсе новых тенденций и исследований в этой области, чтобы сделать качественный выбор продукции для своего ежедневного использования.
Задачи
- Анализ информации по теме исследования
- Проведение лабораторных исследований
- Выявить разницу во влиянии дезодорантов и антиперспирантов на микрофлору человека
Цель:
определить есть ли разница в воздействии ненатуральных и натуральных составов на человеческую микрофлору

На данном этапе мы анализировали существующие работы, выявляя ключевые теории, методы и результаты, которые могут стать основой для нового проекта.
1) Проба 1: с необработанной подмышечный впадины
2) Проба 2: подмышечная впадина после душа
3) Проба 3: после нанесения дезодоранта/антиперспиранта на подмышечную впадину
4) Проба 4: после физической активности (20 минут)
2) Проба 2: подмышечная впадина после душа
3) Проба 3: после нанесения дезодоранта/антиперспиранта на подмышечную впадину
4) Проба 4: после физической активности (20 минут)
1) Проба 1: с необработанной подмышечной впадины
2) Проба 2: с подмышечной впадины после душа
2) Проба 2: с подмышечной впадины после душа
Поиск и анализ информации
Проведение диско-диффузионного метода
Этапы работы
Изучение результатов лабораторного исследования для выявления основных выводов.
Сравнительный анализ полученных данных с существующими знаниями, теориями и гипотезами.
Сравнительный анализ полученных данных с существующими знаниями, теориями и гипотезами.
Изучение и сравнение результатов исследования
Анализ общей обсемененности
Tilda Publishing

Итоги исследования
Диско-диффузный метод
Дезодорант показал бактерицидное действие,а антиперспирант бактериостатическое действие (приостановил рост бактерий и через сутки продолжил рост).
Из этого получается,что естественные компоненты лучше убивают микрофлору, т.к в его состав входят эфирные масла, минералы и растительные экстракты. Антиперспиранты только временно приостанавливают и не убивают бактерии,а лишь ненадолго убирают запах.
*Бактерицидное свойство - полное подавление роста бактерий.
*Бактериостатическое свойство - временное приостановление роста бактерий.
Дезодорант показал бактерицидное действие,а антиперспирант бактериостатическое действие (приостановил рост бактерий и через сутки продолжил рост).
Из этого получается,что естественные компоненты лучше убивают микрофлору, т.к в его состав входят эфирные масла, минералы и растительные экстракты. Антиперспиранты только временно приостанавливают и не убивают бактерии,а лишь ненадолго убирают запах.
*Бактерицидное свойство - полное подавление роста бактерий.
*Бактериостатическое свойство - временное приостановление роста бактерий.
Анализ общей обсемененности
Дезодорант
Проба № 1, № 2 показывают нам нормальную микрофлору человека подмышечной впадины, до и после принятия душа.
Проба № 3 свидетельствует о положительном действии (микроорганизмов стало меньше) косметического средства на микрофлору человека.
Проба № 4 показывает увеличение роста микроорганизмов после физической активности.
Антиперспирант
Проба № 1, № 2 показывают нам нормальную микрофлору человека подмышечной впадины, до и после принятия душа.
Проба № 3 свидетельствует о отрицательном действии (микроорганизмов стало больше) косметического средства на микрофлору человека.
Проба № 4 показывает увеличение роста микроорганизмов после физической активности в два раза больше чем у дезодоранта.
Дезодорант показал, что хорошо борется с микрофлорой даже после физической активности.
Дезодорант
Проба № 1, № 2 показывают нам нормальную микрофлору человека подмышечной впадины, до и после принятия душа.
Проба № 3 свидетельствует о положительном действии (микроорганизмов стало меньше) косметического средства на микрофлору человека.
Проба № 4 показывает увеличение роста микроорганизмов после физической активности.
Антиперспирант
Проба № 1, № 2 показывают нам нормальную микрофлору человека подмышечной впадины, до и после принятия душа.
Проба № 3 свидетельствует о отрицательном действии (микроорганизмов стало больше) косметического средства на микрофлору человека.
Проба № 4 показывает увеличение роста микроорганизмов после физической активности в два раза больше чем у дезодоранта.
Дезодорант показал, что хорошо борется с микрофлорой даже после физической активности.

В ходе сравнения дезодорантов и антиперспирантов мы выявили,что дезодорант эффективнее справляется с запахом пота,а также менее опасен для здоровья.
Если ваша основная проблема-это избыточное потоотделение,лучше выбрать антиперспирант.Если же вас волнует только запах пота и здоровье,отдайте предпочтение дезодоранту
Если ваша основная проблема-это избыточное потоотделение,лучше выбрать антиперспирант.Если же вас волнует только запах пота и здоровье,отдайте предпочтение дезодоранту
Навыки
- Навык проведения бактериологического анализа
- Навык анализа и сравнения
- Навык создания сайта
- Навык работы с лабораторным оборудованием
- Навык создание субстрата
Профессии
- Косметолог
- Врачи-дерматолог
- Микробиолог
- Эколог
- Биолог
- Биохимик
- Молекулярный биолог
Детский технопарк
"Кванториум-15"
"Кванториум-15"
Косметика "Лето"
Крупные компании
по производству
косметики
по производству
косметики
Стейкхолдеры
Магазины
по продаже
косметических средств
по продаже
косметических средств
+79187083831
ar.tedeeva@mail.com
ar.tedeeva@mail.com
Детский технопарк "Кванториум-15" г Владикавказ



